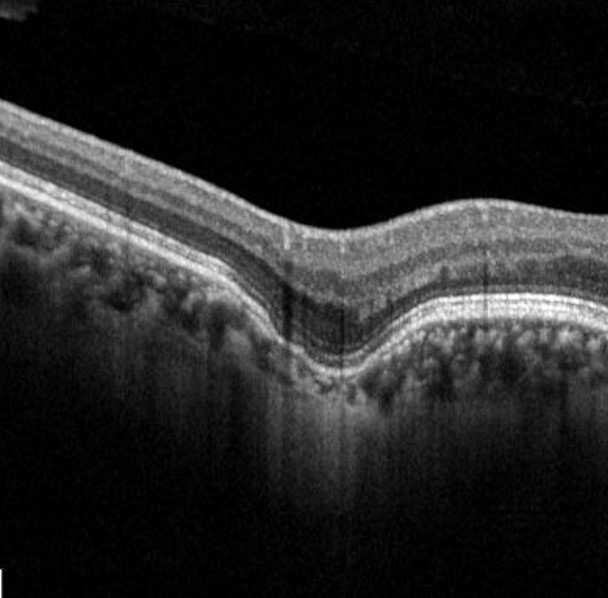

Overview
Focal choroidal excavation presents as an excavation of the choroidal tissue in the absence of any adjacent scleral abnormality/ ectasia and a normal overlying retina. It typically shows minimal change over time and individuals maintain good visual acuity. However, it may be complicated by choroidal neovascularisation in rare cases.
Fundus photos may be normal or show pigmentary changes.
OCT is most useful for the diagnosis of FCE, showing a focal concavity of the choroid with underlying dilated choroidal vessels.
In a conforming FCE, the outer retina conforms to the choroidal excavation with the attachment between the photoreceptors tip and RPE is preserved (two case examples follow). In a non-conforming FCE, the photoreceptor tips and RPE are separated to form a subretinal space.
Case Examples
-
Case 1 (Conforming)
A 44-year-old Asian female with best-corrected visual acuity of 6/7.5+2 (20/25+2) in the right eye.
-
Case 2 (Conforming)
A 26-year-old Asian female with best-corrected visual acuity of 6/6 (20/20) in the right eye.
Differential Diagnosis
References
Borooah, S, Sim, P.Y, Phatak, S, Moraes, G, Wu, C.Y, Cheung, CMG., Pal, B, Bujarborua, D. (2020), Pachychoroid spectrum disease. Acta Ophthalmol.
Cheung, CMG, Lee, WK, Koizumi, H. et al. Pachychoroid disease. Eye 33, 14–33 (2019).


